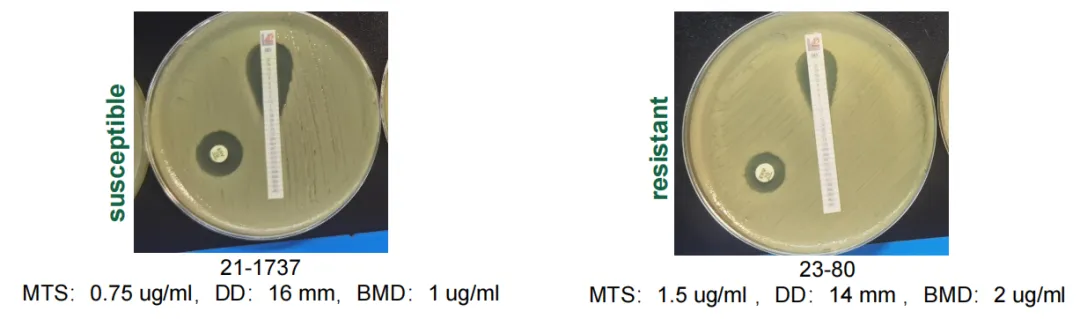

感染医线 发表时间:2024/12/17 11:58:28

编者按:2024年WHO细菌类优先病原体清单中,碳青霉烯耐药鲍曼不动杆菌(CRAB)仍是关键优先级病原体。新型抗菌药为CRAB治疗提供了有力武器,但开展药敏检测是合理用药的重要前提。在近期举行的2024年IDWeek大会上,复旦大学附属华山医院李宁教授团队报告了一项使用最低抑菌浓度测试条(MTS)和纸片扩散法(DD)检测CRAB对依拉环素体外活性的研究,显示MTS和DD与金标准肉汤微量稀释法(BMD)有较好的一致性,且CRAB对依拉环素的敏感率较高。
研究简介
评估CRAB对依拉环素的体外活性:采用肉汤微量稀释法、最低抑菌浓度测试条和纸片扩散法(摘要号:1827574)[1]
背景
依拉环素是一种新型全合成氟环素类药物,是抗菌治疗领域的一大突破。该药物已在多个国家和地区获批。依拉环素可覆盖广泛的病原体,包括常见的革兰阴性菌、革兰阳性菌、厌氧菌和非典型细菌;而且对多种耐药细菌具有活性,如产广谱β-内酰胺酶(ESBLs)或AmpC β-内酰胺酶的肠杆菌目细菌、碳青霉烯耐药肠杆菌(CRE)、碳青霉烯耐药鲍曼不动杆菌(CRAB)、甲氧西林耐药金黄色葡萄球菌(MRSA)和万古霉素耐药肠球菌(VRE)等。
依拉环素的抗菌活性评估可采用多种方法,包括肉汤微量稀释法(BMD)、最低抑菌浓度(MIC)测试条(MTS)、琼脂稀释法和纸片扩散法(DD)。其中,BMD由于在确定药物敏感性方面的精准性而被视为金标准。然而,BMD既耗时又费力,给许多实验室检测带来挑战。相比之下,MTS提供了一种简化的梯度扩散方法,而DD则提供了一种直观的敏感性测试方法。本研究旨在比较使用三种不同测试方法(BMD、MTS和DD)检测依拉环素对CRAB的敏感性。
方法

△ChinaCAST常见细菌对依拉环素的临床折点
结果
在排除缺失值数据并重新评估菌株后,共有587株CRAB分离株纳入分析。如表1所示,对于BMD,MIC50(抑制50%分离株的浓度)为0.5mg/L,MIC90(抑制90%分离株的浓度)为1mg/L。使用BMD检测依拉环素的敏感率为98.13%(576/587分离株),无中介分离株,11株(1.87%)为非敏感。对于MTS方法,MIC50确定为0.38mg/L,MIC90为0.75mg/L。MTS的敏感率为97.96%(575/587分离株),无中介菌株,非敏感率为2.04%(12/587)。DD方法的敏感率为97.61%(573/587分离株),非敏感率为2.39%(14/587分离株),无中介菌株。
表1. 三种方法所测得的药敏结果

表2. 三种方法的错误率和一致率

通过BMD和MTS获得的MIC值分布模式以及DD获得的抑菌圈直径分布模式分别如图1和图2所示。如表2所示,可靠性指标显示MTS的EA率为94.55%,表明与BMD的一致性良好。MTS和DD的CA率分别为99.83%和99.49%,表明敏感性分类的准确性很高。两种方法的ME率都很低(TS为0.17%,DD为0.51%),没有VME。由于测试的分离株中没有中介菌株,因此无法评估mE。
图1. 展示MTS和DD敏感性和耐药性结果的代表性图片

图2. 通过BMD和MTS方法测得的MIC分布

图3. 通过BMD测得的MIC分布和通过DD测得的抑菌圈直径分布
结论
依拉环素对于CRAB的敏感率较高,MTS和DD方法与BMD非常一致。研究结果支持在临床微生物实验室中使用MTS和DD作为可靠而实用的方法来确定对依拉环素的敏感性。
研究者说
在最新发布的2024版WHO P
药敏检测方法及折点对指导临床抗菌药选择至关重要。替加环素、多黏菌素尚缺乏中国折点,且替加环素的FDA折点已近20年没有更新,与EUCAST折点有差异,导致国内用药缺乏明确的合理的参考标准。中国ChinaCAST于2024年初确定了依拉环素的折点,为中国临床实践提供了最新的参考标准。我们这项研究也提示更加简便易行的MTS和DD,与金标准BMD有较高的一致性和准确性。临床折点的确立以及简便易行的药敏检测方法,为临床广泛检测依拉环素药敏提供了有力条件。因此,微生物室可常规进行依拉环素的药敏检测。从上述体外研究到真实世界研究,依拉环素对常见CRE、CRAB等保持较强的活性。真实世界中依拉环素被应用于不同部位的感染治疗,具有广谱、高效的治疗优势。这些数据表明依拉环素在耐药菌感染的治疗中有重要价值,为当前多重耐药感染治疗提供新的有效方案。

▌参考文献:
[1]Liu Qihui, et al. In Vitro Activity of Eravacycline against Carbapenem-resistant Acinetobacter Baumannil as Evaluated by Broth Microdilution, MlC Test Strip and Disc Diffusion. IDWeek 2024,poster No.1827574
[2]WHO bacterial priority pathogens list, 2024.https://www.who.int/publications/b/64088
[3]国家卫生健康委临床抗微生物药物敏感性折点研究和标准制定专家委员会.依拉环素临床折点
[4]国家卫生健康委抗菌药物临床应用与耐药评价专家委员会.《依拉环素临床应用综合评价项目》结题报告.https://www.kdocs.cn/l/cq3aZeQFQpvh

李宁 教授
复旦大学医学博士、主任医师、 硕士研究生导师
复旦大学附属华山医院虹桥院区感染科执行主任
美国City of Hope访问学者
国家重点专科建设项目(中枢神经系统感染多学科精准救治平台建设)学科带头人
上海市闵行领军人才
主持国家自然科学基金2项、中科院课题1项;
参与国家十一五、十二五、十三五重大专项课题,科技部973课题
亚太医学生物免疫学会委员
中华医学会内科学分会青年委员
中华医学会热带病与寄生虫学分会肝炎学组委员
上海市临床流行病学与循证医学分会委员
上海市医学病毒学分会委员
上海市药学会专业委员会委员
上海市医学会中西医结合感染病/肝病分会委员
来源:《感染
声 明
凡署名原创的文章版权属《感染医线》所有,欢迎分享、转载(开白可后台留言)。本文仅供医疗卫生专业人士了解最新医药资讯参考使用,不代表本平台观点。该等信息不能以任何方式取代专业的医疗指导,也不应被视为诊疗建议,如果该信息被用于资讯以外的目的,本站及作者不承担相关责任。
